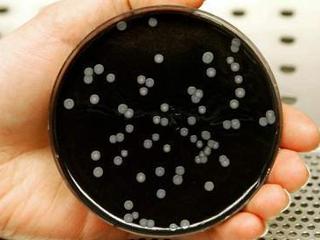
军团菌病

军团菌感染

唐绍宏老师探索:军团菌肺炎影像表现(多图示)
图片尺寸960x720
人长时间呆在这样不通风的环境中,就会感染"军团菌肺炎",出现头疼
图片尺寸640x853
军团菌肺炎——高占成病例
图片尺寸1080x746
军团菌病
图片尺寸393x295
军团菌病病原嗜肺军团菌照片
图片尺寸533x300
突发!多伦多大学多栋建筑出现致命病菌"军团菌"
图片尺寸640x392
辅助检查:已做皮肤病理与抗酸染色,组织液真菌培养.等待结果中.
图片尺寸3456x2304
有没有做过嗜肺军团菌的朋友,求bcye上嗜肺军团菌图片
图片尺寸1944x2592
军团菌病
图片尺寸320x240
唐绍宏老师探索:军团菌肺炎影像表现(多图示)
图片尺寸960x720
37岁男子吹空调感染军团菌,icu住了一周未脱险,你家空调有多久没清洗
图片尺寸720x561
军团菌肺炎有多可怕:男子开长霉的车细菌感染住进icu
图片尺寸1919x1067
嗜肺军团菌(图片来源:美国疾病控制及
图片尺寸390x293
军团菌病ppt幻灯片
图片尺寸1080x810
卫生局接获一例军团菌病报告
图片尺寸550x310
美国军团病暴发 来看看北京的情况|感染|军团菌|疾病_新浪育儿_新浪网
图片尺寸408x273
曝了晋中美域酒店百人温泉后住院高度怀疑军团菌感染晋中市卫健委发布
图片尺寸589x922
军团菌是一种广泛存在于自然界中的机会致病菌,能引起以发热和呼吸
图片尺寸1118x644
军团菌肺炎的临床表现
图片尺寸419x273
军团菌病病原嗜肺军团菌
图片尺寸700x394